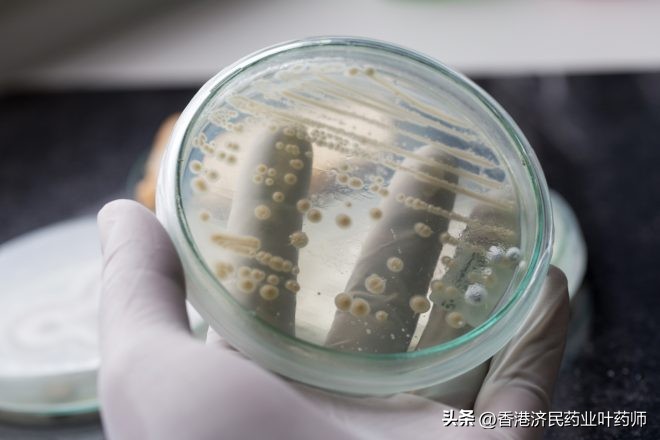
外阴念珠菌感染能自愈吗,外阴念珠菌病怎么防止复发

当一年内发生至少4次特定发作或一年内发生至少3次与抗生素治疗无关的发作时,外阴阴道念珠菌病被视为复发性。在急性发作治疗后,后续的预防很重要。因为一旦停止预防,许多患者会经历复发。现在,FDA批准了一种抗真菌治疗方案,该方案经证明可减少女性反复阴道酵母菌感染的复发。
SCYNEXIS于12月1日宣布,美国食品和药物管理局(FDA)已批准非唑类口服片剂BREXAFEMME(ibrexafunerp)的第二个适应症,用于减少复发性外阴阴道念珠菌病(RVVC)的发病率。
此前,该药于2021年6月获批,用于治疗外阴阴道念珠菌病。现在,这是第一个也是唯一一个获得FDA批准的抗真菌药物,可同时治疗外阴阴道念珠菌病和预防复发性外阴阴道念珠菌病。

第二个适应症的批准是在对随机、双盲、安慰剂对照CANDLE研究(NCT04029116)的第3阶段数据进行审查后得出的,该研究评估了每月服用ibrexafungerp以减少酵母菌感染复发的安全性和有效性。
试验结果显示,在接受ibrexafungerp治疗的患者中,65.4%的患者在24周研究期间没有出现外阴阴道念珠菌病复发,无论是培养证明的、推定的还是可疑的。相比之下,53.1%的安慰剂接受者没有复发。
通过葡聚糖合成酶抑制作用,ibrexafungerp对念珠菌属物种具有杀真菌作用并杀死其细胞。研究者注意到,在整个3个月的随访期内,ibrexafungerp在统计学上仍然比安慰剂更有益。
此外,ibrexafunerp耐受性良好,常见的不良事件包括头痛、腹泻和恶心,这些不良事件通常较轻微且与药物的当前标签一致。非唑类药物通常也具有良好的耐受性和安全性,报告最多的不良事件是头痛或胃肠道相关(即腹泻、恶心)。不良事件也与之前的Brexafemme标签大体一致。
参考来源:‘SCYNEXIS Announces FDA Approval of Second Indication for BREXAFEMME® (ibrexafungerp tablets) for Reduction in Incidence of Recurrent Vulvovaginal Candidiasis’,新闻发布。SCYNEXIS, Inc.;2022年12月1日发布。
注:本文旨在介绍医药健康研究,不作任何用药依据,具体用药指引,请咨询主治医师。